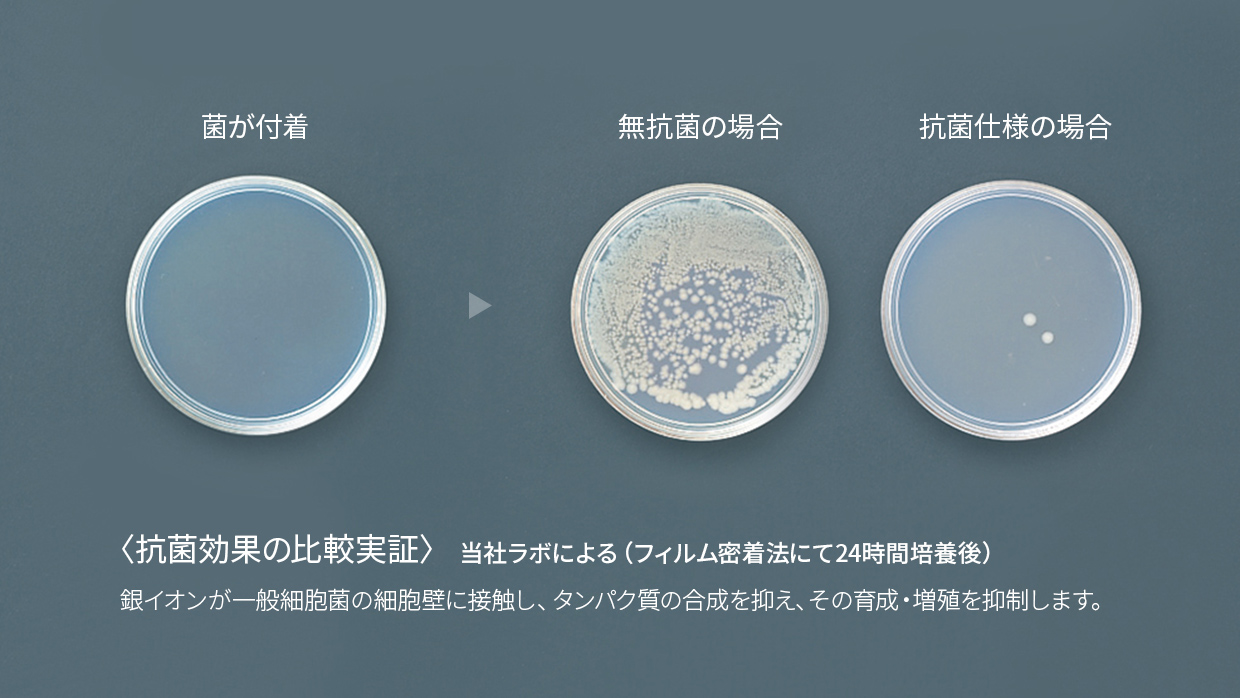
抗菌効果の比較実証

お手頃で導入しやすい、1日使用回数400回以下モデル!
さまざまなサニタリーに調和するスクエアデザイン
主な仕様
-
乾燥方法:両面ジェット乾燥
-
外形寸法(mm) :幅300×奥行219×高さ670
-
モーター種類:整流子モーター
-
製品特長
-
製品仕様

お求めやすい標準モデル。
低使用頻度で、両面タイプを導入したい方にもおすすめ。
衛生面にしっかり配慮
「全面」※1抗菌加工樹脂&「全面」※1アルコール※2拭き清掃可能
標準モデルでも、ジェットタオルは高い衛生性を追求しています。気になる菌の繁殖を抑える抗菌加工に加え、アルコール拭き清掃に耐える樹脂も新たに本体全面※1にダブル採用。まるごとらく楽キレイにしておけて、ますます快適にご利用いただけます。
- ※1背面部、底面部、スイッチドア内部を除く。
- ※2アルコールとは日本薬局方消毒用エタノール(濃度76.9~81.4%)を指します。

- SIAAマークは、ISO22196法により評価された結果に基づき、抗菌製品技術協議会ガイドラインで品質管理・情報公開された製品に表示されています。
風量は無段階調整可能
パワーコントロールボリューム搭載
使用シーンに合わせて無段階で風量を設定可能。スピード重視の[強]から静かさ重視の[弱]まで、簡単に最適な運転モードを選べます。

| モード | 弱〜強 |
|---|---|
|
乾燥時間 |
[10~15秒]~[3~5秒] |
|
運転音※ |
49dB~56dB |
|
用途 |
低騒音運転重視~早く乾かしたい |
- ※無響室で2m離れた位置での測定(JT-HC116JH2-Wの場合)

お問い合わせ
「スリムタイプ<速乾モデル>」を導入して経費削減と利用者利便向上を実現しませんか?
設計・工事の専門家のお問い合わせはこちら
ジェットタオルの特長
手を入れやすく、お手入れしやすい。
「サイドオープン設計」

両側面が開放された独自のスタイル。
だからとても使いやすく、お掃除もしやすい!
使う回数が多くても安定作動。
「DCブラシレスモーター」

ブラシとローターに磨耗が発生しないので効率よくパワーを発揮でき、長期間の安定した作動を維持します。
- DCブラシレスモーター:スリムタイプ(衛生強化モデル/速乾モデル)に採用
- 整流子モーター:スリムタイプ(標準モデル)、ジェットタオルミニ、ジェットタオルプチに採用
菌の繁殖をまるごと抑制。
「全面*抗菌加工※1樹脂」採用

手挿入部やドレンタンク・ドレン水路はもちろん、本体全面*に抗菌加工※1樹脂を採用し、いつでも気持ちよくお使いいただけます。
- *スリムタイプ(衛生強化モデル)の場合:背面部、底面部、メンテナンスパネル内部を除く。
スリムタイプ(速乾モデル・標準モデル)の場合:背面部、底面部、スイッチドア内部を除く。
ジェットタオルミニの場合:背面部、ノズル部、スイッチカバー内部を除く。
ジェットタオルプチ(壁取付タイプ)の場合:ノズル部、センサー部、天面シート、取付板を除く。 - ※1SIAA抗菌マーク(ISO22196)を取得。
独立風路でいつも新鮮な風。
「独立風路方式」

吸気口/風路とドレン水路を分離。新鮮な空気だけ取り込むことで、いつもきれいな風で乾かせます。
- *全タイプに採用。
ハンドドライヤー導入のメリット




環境のために紙ごみゼロ
ジェットの風で手を乾かすジェットタオルなら、ペーパータオルのような紙ごみを一切出さないので、ごみ処理のお悩みも解消。森林資源を大切にすることで、企業イメージUPにも貢献します。
- 10階建てビルにペーパータオルを20ヶ所設置したと想定。ペーパータオル1枚の質量を約2.1gとし、1回で2枚使用。ペーパータオル1ヶ所あたり400回/日使用とし、1ヵ月の稼働日25日でペーパータオル消費量を40万枚とした場合。
- *ペーパータオルは再生紙を使用している場合も多いため、必ずしも環境破壊に繋がる訳ではありません。

経営者の方のためにコスト大幅削減
月々の費用は、わずかな電気代だけ(JT-SB116MN-Wでは10円で300回使用可能)。ペーパータオルや布ロールタオルで必要な補充・交換のコストもまるごと削減できます。長期間使うほど、ますますおトク!

ご利用されるお客様のためにサービス向上
さまざまな施設やお店のサニタリーでも大好評です。管理のコスト・手間を抑えながら、快適な速乾や清潔なサニタリー環境などで好感度もアップ。これからのサービス向上にぜひお役立てください。
納入事例
お客様の声
-
ハンドドライヤーは常盤橋タワーのような大規模施設に必要な設備です。手洗い後にさっと手を乾かすことができて快適ですし、濡れた手でいろんな場所を触ることも無くなるので衛生的です。ペーパータオルと違い、水が周囲にポタポタ垂れることも減り、紙ゴミが出ることもないので、コスト面のメリットもあります。
常盤橋タワーは就業者の皆様が安心して働ける環境づくりを重視しており、衛生面に関してさまざまな配慮のある「衛生強化モデル」は、ユーザーや入居企業に対して説得力があると感じました。
コロナ下において、衛生環境への関心は確実に高まっています。そんな中でオフィスを探している企業に対して、「このビルは衛生に配慮しています」と具体的に示せる材料が多ければ多いほど、私たちの強みとなります。ハンドドライヤーはその一つですね。
ジェットタオル30年のあゆみ

ご相談・お問い合わせ












